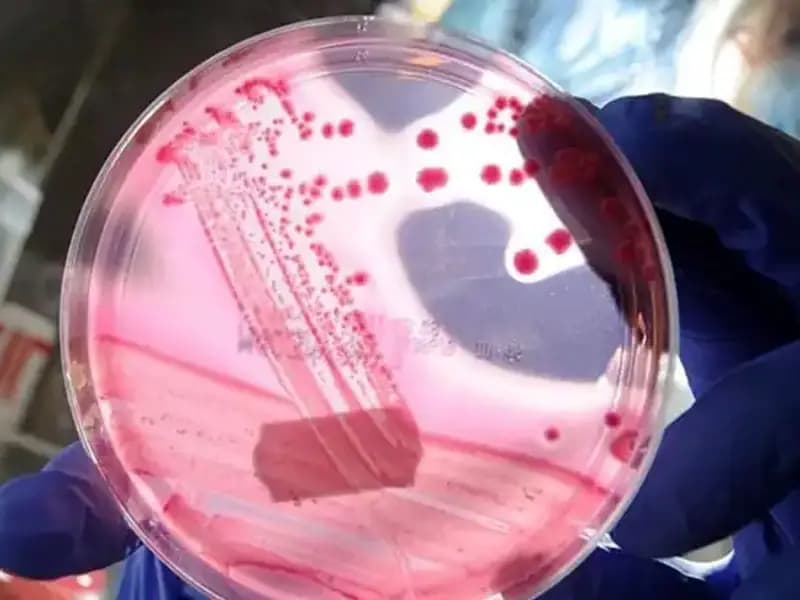
Bilim İnsanları, AP2A1 Proteini ile Yaşlanmayı Geri Almanın Yolunu Buldu!

Saglik
Bilim İnsanları, AP2A1 Proteini ile Yaşlanmayı Geri Almanın Yolunu Buldu!

Yaşlanma, insanlık tarihinin en karmaşık ve en az anlaşılan süreçlerinden biri olmuştur. Son yıllarda bilim insanları, yaşlanma sürecini anlamak ve bu süreci yavaşlatmak amacıyla birçok araştırma gerçekleştirdi. Özelikle son dönemde AP2A1 proteini üzerine yapılan çalışmalar, yaşlanmayı unutturucu potansiyelini ortaya koymaya başladı. Peki, AP2A1 proteini nedir ve nasıl baskılanır? Bu soruların yanıtları, yaşlanma karşıtı araştırmaların geleceği açısından büyük önem taşıyor.
AP2A1 Proteini Nedir?
AP2A1, hücrelerin iç yapısı ve işlevselliği üzerinde önemli bir role sahip olan bir proteindir. Bu protein, hücrelerin sinyal iletiminde, maddelerin taşınmasında ve hücresel yanıtların düzenlenmesinde kritik bir işlev görür. Yaşlanma ile birlikte, AP2A1'in işlevselliğinde önemli değişiklikler gözlemlenir. Araştırmalar, AP2A1'in yaşlanma sürecinde bazı moleküler yoldaşlarla etkileşime geçerek yaşa bağlı zararı hafifletebileceğini göstermektedir. Bu durum, yaşlanmanın genetik ve çevresel faktörlerle nasıl etkileşimde bulunduğu konusunda yeni ipuçları sunmaktadır.
AP2A1’in Baskılanma Mekanizmaları
Bilim insanları, AP2A1 proteininin yaşlanma üzerindeki etkilerini azaltmanın yollarını arıyor. Yapılan araştırmalar gösteriyor ki, belirli genler ve proteinler AP2A1’in aktivitesini baskılayabiliyor. Özellikle yaşlanma sürecinde artan oksidatif stres, AP2A1’in işlevselliğini olumsuz etkiliyor. Dolayısıyla, oksidatif strese karşı dirençler geliştirmek ve bu stresi azaltmak, AP2A1’i koruma altına almak açısından büyük önem taşıyor. Bunun yanı sıra, bazı besin takviyelerinin ve doğal bileşenlerin de AP2A1'in baskılanmasını azaltabileceği düşünülüyor.
Son olarak, AP2A1 üzerine yapılan bu keşif, yalnızca yaşlanmayı yavaşlatmakla kalmayıp, aynı zamanda yaşlılıkla ilgili hastalıkların önlenmesi ve tedavisinde yeni stratejilerin de gelişmesine olanak tanıyabilir. Yaşlanmanın önlenmesi ya da geciktirilmesi üzerine yapılan bu tür çalışmalara duyulan ilgi, bilim dünyasının gelecekte daha sağlıklı bir yaşlılık dönemi geçirebilmek için çaba harcamaya devam edeceğinin bir göstergesi.
Bilinçli beslenme, düzenli egzersiz ve stres yönetimi gibi yaşam tarzı faktörlerinin de yaşlanma sürecini yavaşlatabileceği biliniyor. Ancak AP2A1 proteininin rolü, bu süreçlerin bilimsel temellere dayandığını gösteriyor. Gelecek araştırmaların, AP2A1'in diğer biyolojik işlevleri ve yaşlanma üzerindeki etkilerini daha kapsamlı bir şekilde anlamamıza yardımcı olacağı umut ediliyor. Bilim insanları, bu önemli proteinin mekanizmalarını çözerek, yaşlanmayı unutturacak stratejiler geliştirebilir ve insan ömrünü uzatmayı hedefleyebilir.
Sonuç olarak, yaşlanma sürecini anlamak ve kontrol altına almak, insanlık için her zaman önemli bir hedef olmuştur. Teknolojinin ve bilimsel araştırmaların ilerlemesi ile AP2A1 proteini gibi hayati moleküller üzerinde yapılan çalışmalar, önemli buluşlara zemin hazırlayabilir. AP2A1’in yaşlılık açısından sunduğu potansiyel, gelecekte yeni tedavi yöntemlerinin gelişmesine katkıda bulunabilir. Akıllıca yönlendirilen araştırmalarla, hepimizin daha sağlıklı ve uzun bir yaşam sürmesi mümkün olabilir.